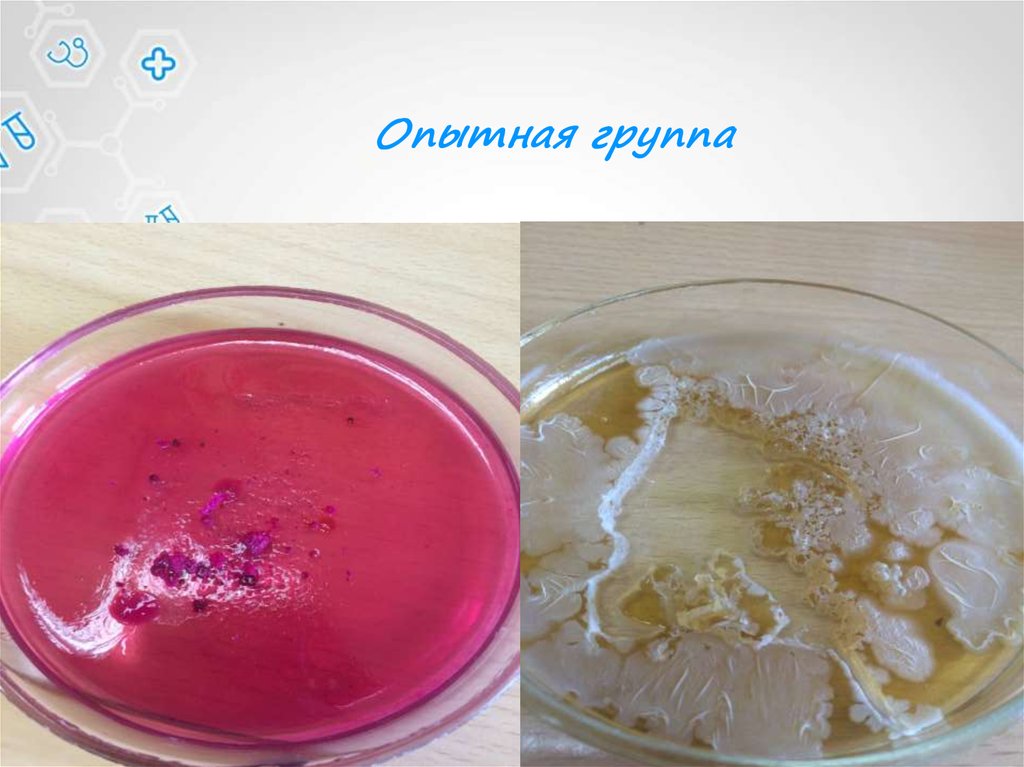

Похожие презентации:
Можно ли употреблять пищу, которая подверглась сильному загрязнению
1. Задача №6 Что упало – то пропало
КОМАНДА «NONSTOP» Г. ВОРОНЕЖЗОТОВА АНАСТАСИЯ
ЧТО
ЗАДАЧА №6
УПАЛО – ТО ПРОПАЛО
2. Условие задачи
Существует мнение, что если что-тосъедобное уронить на пол и поднять
меньше чем через 30 секунд, то его все
еще можно есть. Рассчитайте скорость
перемещения бактерий с одной
поверхности на другую. Поставьте
эксперимент.
3. Цель
В ходе эксперимента выявить,можно ли употреблять пищу,
которая подверглась сильному
загрязнению.
4. Задачи
1) Сделать посевы с загрязненногопродукта питания и одноименного
свежего
2) Произвести микробиологические
мазки на определение полученных
культур
3) Сравнить полученные результаты
4) Сделать вывод о степени риска
употребления
5) Оценить возможность расчета
скорости передвижения
микроорганизмов с поверхности на
поверхность
5.
Для установления достоверностигипотезы «30 секунд» был поставлен
эксперимент.
Условия проведения опыта были
максимально приближены к
естественным.
6. Постановка эксперимента
Шаг 1. Покупка опытногообразца
7. Постановка эксперимента
Шаг 2. Произведение посева напитательные среды Эндо и МПА
8. Контрольная группа
9. Опытная группа
10.
Шаг 3. Посевы хранились втермостате при t=37◦C
2 суток
11. Шаг 4. Анализ полученных колоний, произведение мазков и микроскопирование на определение рода
Контрольная группа12.
Опытная группа13. Шаг 5. Произведение окраски по Граму
14. Шаг 6. Определение родовой принадлежности
15.
На контрольном и опытномобразцах на среде Эндо
обнаружены:
1) Хаотично расположенные Гркороткие тонкие палочки с
закругленными концами и жгутиками
Это свидетельствует о присутствии
рода Escherichia.
2) Различие между контрольным и
опытным образцом состоит в разном
числе колоний
16.
На контрольном и опытномобразцах на среде Эндо
обнаружены:
1) Расположенные гроздьями Гр+
шаровидные неподвижные клетки.
Это предположительно говорит о
присутствии рода Staphylococcus.
2) Различие между контрольным и
опытным образцом состоит в
разном числе колоний
3) В опытном образце найдены
расположенные цепочками Гр+
шаровидные неподвижные клетки.
Это предположительно говорит о
присутствии рода Streptococcus.
17. Путешествие по поверхностям
Отвечая на вопрос задачи оскорости передвижения бактерий
с поверхности на поверхность,
можно сказать, что :
1) У родов Streptococcus и
Staphylococcus она равна 0
2) У рода Escherichia она варьирует
от 0 до скорости активности
переносчика бактерии.
18. Патогенны ли?
Судить о степени патогенности вида мы можемтолько после проведения лабораторных тестов!!!
1)
2)
3)
Наиболее патогенны для человека гемолитические
S. pyogenes. Этот вид вызывает у человека многие
болезни: скарлатину, ангину, острый эндокардит,
послеродовой сепсис, хронический тонзиллит,
ревматизм.
У стафилококков около 120 клинических форм
проявления, которые имеют местный,
системный или генерализованный характер. К
ним относятся гнойно-воспалительные болезни
кожи и мягких тканей (фурункулы, абсцессы),
поражения глаз, уха, носоглотки, урогенитального тракта, пищеварительной
системы (интоксикации).
При эшерихиозе болезнь начинается остро, с
повышения температуры тела, болей в животе,
поноса, рвоты. Отмечаются нарушение сна и
аппетита, головная боль.
19. Путешествие по поверхностям
Отвечая на вопрос задачи оскорости передвижения бактерий с
поверхности на поверхность,
можно сказать, что :
1) У родов Streptococcus и
Staphylococcus она равна 0 из-за
отсутствия жгутиков
2) У рода Escherichia она варьирует
от 0 до скорости активности
переносчика бактерии, впрочем,
как и у 2х вышеперечисленных
родов.
20. Вывод:
Таким образом, поднятие еды спола и ее употребление сравнимо
с русской рулеткой. Все зависит
от того, какой микроорганизм
попал на пищу, и насколько силен
иммунитет гурмана.

Медицина
Медицина








